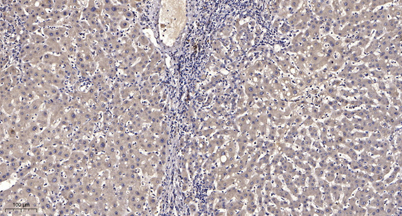

$148.00/50µL $248.00/100µL
| 50 µL | $148.00 |
| 100 µL | $248.00 |
| Product name: | MIP-1β rabbit pAb |
| Reactivity: | Human;Rat;Mouse; |
| Alternative Names: | CCL4; LAG1; MIP1B; SCYA4; C-C motif chemokine 4; G-26 T-lymphocyte-secreted protein; HC21; Lymphocyte activation gene 1 protein; LAG-1; MIP-1-beta(1-69);Macrophage inflammatory protein 1-beta; MIP-1-beta; PAT 744; Protein H400; SIS-gamma; Small-inducible cytokine A4; T-cell activation protein 2; ACT-2 |
| Source: | Rabbit |
| Dilutions: | WB 1:500-2000;IHC-p 1:50-300 |
| Immunogen: | The antiserum was produced against synthesized peptide derived from the Internal region of human CCL4. AA range:41-90 |
| Storage: | -20°C/1 year |
| Clonality: | Polyclonal |
| Isotype: | IgG |
| Concentration: | 1 mg/ml |
| Observed Band: | 16kD |
| GeneID: | 388372 |
| Human Swiss-Prot No: | P13236 |
| Cellular localization: | Secreted. |
| Background: | The protein encoded by this gene is a mitogen-inducible monokine and is one of the major HIV-suppressive factors produced by CD8+ T-cells. The encoded protein is secreted and has chemokinetic and inflammatory functions. [provided by RefSeq, Dec 2012], |